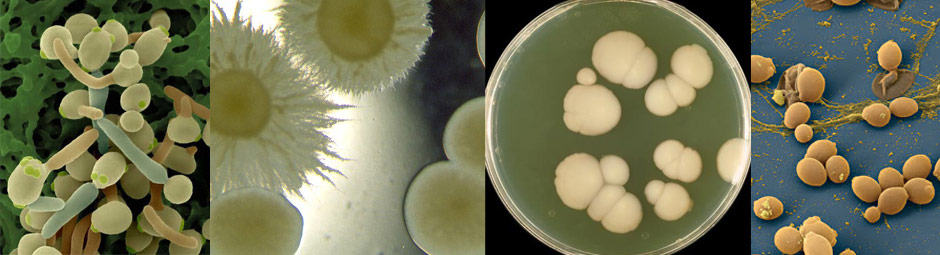
Candida albicans

Los fungicidas son sustancias tóxicas que se emplean para impedir el crecimiento o eliminar los hongos y mohos perjudiciales para las plantas, los animales o el hombre. Todo fungicida, por más eficaz que sea, si se utiliza en exceso puede causar daños fisiológicos a la planta. Como todo producto químico, debe ser utilizado con precaución para evitar cualquier daño a la salud humana, a los animales y al medio ambiente. Se aplican mediante rociado, pulverizado, por revestimiento, o por fumigación de locales. Para tratamientos de otros materiales como madera, papel, cuero...se aplican mediante impregnación o tinción. Otra forma de administrarse, es a modo de medicamentos (ingeridos o aplicados), en tratamiento de enfermedades humanas o animales. La mayoría de los fungicidas de uso agrícola se fumigan o espolvorean sobre las semillas, hojas o frutas para impedir la propagación de la roya, el tizón, los mohos, o el mildiu (enfermedades de las plantas). Existen tres enfermedades graves causadas por hongos que hoy pueden ser combatidas por medio de fungicidas, son la roya del trigo, el tizón del maíz y la enfermedad de la patata, que causó la hambruna de la década de 1840 en Irlanda. Los fungicidas se pueden clasificar según su modo de acción, su composición y su campo de aplicación.
En este proyecto se ha determinado el espectro de acción de prototipos SANIERS diseñados para desinfectar biberones sumergidos en agua mediante ozonización. De acuerdo con el objetivo del prototipo SANIERS, en el espectro de actividad antimicrobiana se han incluido cepas bacterianas que podrían producir trastornos gastrointestinales y de salud en general por vía oral. El prototipo de ozonización SANIERS resultó altamente eficaz a la hora de desinfectar agua contaminada con diversas especies bacterianas en suspensión. Un solo ciclo de 10 minutos de ozonización fue suficiente para reducir de 5 a 6 logaritmos la carga bacteriana, lo cual se sitúa por encima incluso de las exigencias establecidas por la agencia AFNOR sobre actividad de Antisépticos y desinfectantes (AFNOR, Antiseptiques et désinfectants: Normes et reglementation). De igual modo, la actividad del ozonizador resultó eficaz frente a hongos y levaduras, partículas víricas, e incluso frente a esporas de Geobacillus stearothermophillus. En este último caso, fue necesario aplicar dos ciclos de ozonización de 10 minutos para conseguir la desinfección. A continuación se muestran los resultados obtenidos. Las tablas reflejan los recuentos de bacterias obtenidos antes y después de la ozonización en tres experimentos independientes.
Candida albicans es un hongo diploide asexual (forma de levadura) saprófito de la familia de los Sacaromicetos. Normalmente se encuentra en la cavidad oral, en el tracto gastrointestinal y en la vagina. Está envuelta en un rol relevante en la digestión de los azúcares mediante un proceso de fermentación.
Candida albicans puede asumir patogeneidad provocando la candidiasis; en ese caso se presenta como una afección vaginal (vaginitis), de la cavidad oral (muguet), del intestino o de la piel. En un físico debilitado, inmunodeprimido o convaleciente de un larga cura antibiótica, la Candida se multiplica en modo anómalo y, atraviesa el intestino, para entrar al torrente sanguíneo, donde libera sus propias toxinas provocando la candidemia. Este fenómeno da lugar a síntomas algunos abdominales, mala digestión, gases e hichazón, molestias intestinales (estreñimiento o diarrea), intolerancia alimentaria, irritabilidad, insomnio, pérdida de la memoria, dolores de cabeza y depresión. La candidosis induce también una disminución de la absorción de las sustancias nutritivas por lo que se podría producir un estado de malnutrición.



Mucor es un género de hongos de la familia Mucoraceae, orden Mucorales, que forman delicados filamentos tubulares blancos y esporangios negros esféricos.M. racemosus es un moho del suelo y de los frutos enfermos, aislado ocasionalmente de casos de otomicosis.



Aspergillus niger es un hongo que produce un moho negro en vegetales -muy común en la lechuga, el tomate o la acelga-. Es una de las especies más corrientes del género Aspergillus. El Aspergillus es un género de alrededor de 200 hongos. Puede existir en dos formas básicas: levaduras e hifas. El Aspergillus es filamentoso (compuesto de cadenas de células, llamadas hifas, el tipo de hongos opuesto a las levaduras, que se componen de una sola célula redonda). En 1729 los catalogó por primera vez el biólogo italiano Micheli. Y su hábitat natural es el heno y el compostaje.
Aspergillus niger no causa tantas enfermedades como otras especies de Aspergillus, pero en altas concentraciones puede producir aspergilosis, que provoca alteraciones pulmonares. Esta enfermedad aparece con más frecuencia en horticultores, ya que inhalan el polvo del hongo con más facilidad.


Ejemplo de la actividad fungicida del equipo ozonizador SANIERS: Placas de petri en las que se han incubado las membranas procedentes de la filtración de 100 ml de agua contaminada con el hongo Aspergillus níger y después del tratamiento de ozonización durante 10 minutos.
